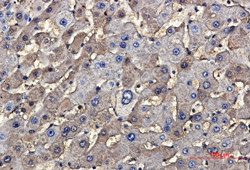
TSC2 Antibody in Immunohistochemistry (Paraffin) (IHC (P))

Search
Abnova
TSC2 Recombinant Rabbit Monoclonal Antibody
{{$productOrderCtrl.translations['antibody.pdp.commerceCard.promotion.promotions']}}
{{$productOrderCtrl.translations['antibody.pdp.commerceCard.promotion.viewpromo']}}
{{$productOrderCtrl.translations['antibody.pdp.commerceCard.promotion.promocode']}}: {{promo.promoCode}} {{promo.promoTitle}} {{promo.promoDescription}}. {{$productOrderCtrl.translations['antibody.pdp.commerceCard.promotion.learnmore']}}


Please note: We are reviewing Western blot images included in the antibody testing data in our catalog, including those provided by third parties. Unless expressly labeled or annotated as “raw-unedited”, Western blot images included in the antibody testing data in our catalog may have been edited, optimized or otherwise adjusted for presentation.
产品信息
RAB01341
种属反应
宿主/亚型
Expression System
分类
类型
抗原
偶联物
形式
纯化类型
保存液
内含物
保存条件
运输条件
靶标信息
TSC2 (Tuberin, Tuberous sclerosis complex, TSC Complex Subunit 2), is implicated as a tumor suppressor and may function in vesicular transport, play a role in the regulation of cell growth arrest and in the regulation of transcription mediated by steroid receptors. TSC2 associates with hamartin in a cytosolic complex, possibly acting as a chaperone for hamartin. Phosphorylation of tuberin on Ser 939 and Thr 1462 regulates its interaction with hamartin, and is stimulated by various growth factors through the phosphoinositide 3-kinase/Akt pathway. TSC2 may have a function in vesicular transport, but may also play a role in the regulation of cell growth arrest and in the regulation of transcription mediated by steroid receptors. Interaction between TSC1 and TSC2 may facilitate vesicular docking. TSC2 specifically stimulates the intrinsic GTPase activity of the Ras related protein RAP1A and RAB5, suggesting a possible mechanism for its role in regulating cellular growth. Mutations in TSC2 lead to constitutive activation of RAP1A in tumors and are involved in diseases such as lymphangioleiomyomatosis and TSC2 angiomyolipoma. Alternative splicing results in transcript variants of three different isoforms of TSC2.
仅用于科研。不用于诊断过程。未经明确授权不得转售。
篇参考文献 (0)
生物信息学
蛋白别名: OTTHUMP00000198394; Tuberin; Tuberous sclerosis 2 protein
基因别名: TSC2; TSC4
Entrez Gene ID: (Human) 7249